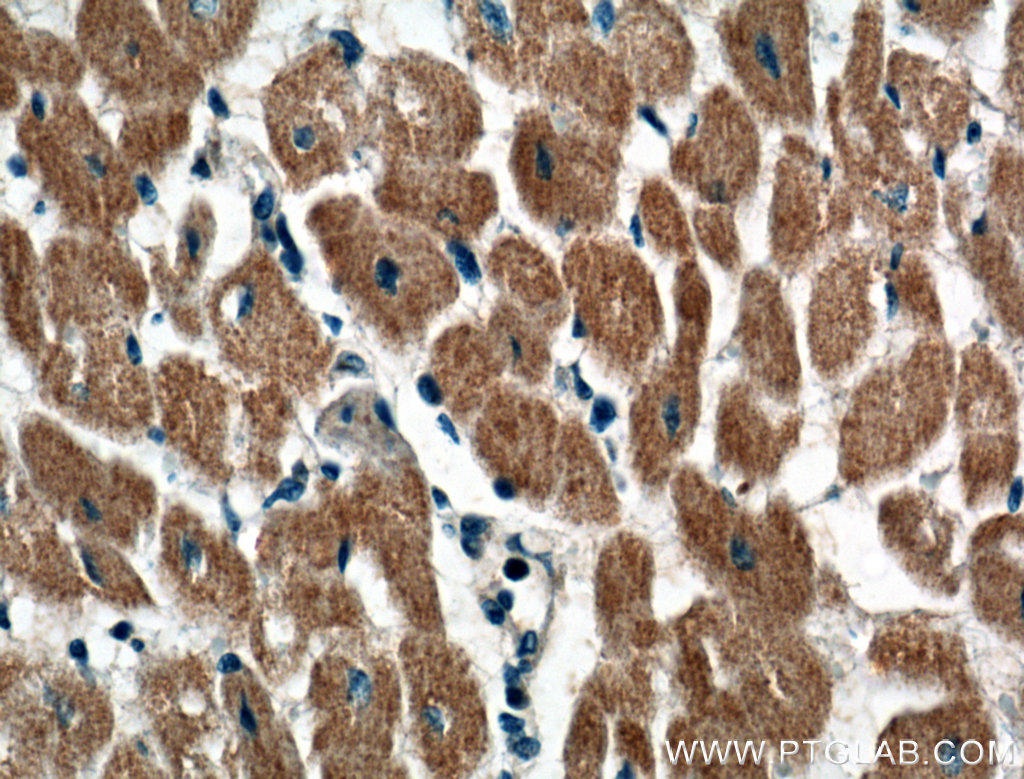

验证数据展示
经过测试的应用
| Positive WB detected in | A549 cells, HEK-293T cells, HepG2 cells, Jurkat cells |
| Positive IHC detected in | human heart tissue, human liver cancer tissue, human skeletal muscle tissue Note: suggested antigen retrieval with TE buffer pH 9.0; (*) Alternatively, antigen retrieval may be performed with citrate buffer pH 6.0 |
推荐稀释比
| 应用 | 推荐稀释比 |
|---|---|
| Western Blot (WB) | WB : 1:500-1:3000 |
| Immunohistochemistry (IHC) | IHC : 1:50-1:500 |
| It is recommended that this reagent should be titrated in each testing system to obtain optimal results. | |
| Sample-dependent, Check data in validation data gallery. | |
产品信息
14845-1-AP targets CRLS1-Specific in WB, IF, IHC, ELISA applications and shows reactivity with human samples.
| 经测试应用 | WB, IHC, ELISA Application Description |
| 文献引用应用 | WB, IF |
| 经测试反应性 | human |
| 文献引用反应性 | human, mouse, rat |
| 免疫原 |
Peptide 种属同源性预测 |
| 宿主/亚型 | Rabbit / IgG |
| 抗体类别 | Polyclonal |
| 产品类型 | Antibody |
| 全称 | cardiolipin synthase 1 |
| 别名 | C20orf155, Cardiolipin synthase, cardiolipin synthase 1, CLS, CLS1, CRLS1, CRLS1-Specific, GCD10, Protein GCD10 homolog |
| 计算分子量 | 33 kDa |
| 观测分子量 | 32 kDa |
| GenBank蛋白编号 | NM_019095 |
| 基因名称 | CRLS1 |
| Gene ID (NCBI) | 54675 |
| RRID | AB_2085336 |
| 偶联类型 | Unconjugated |
| 形式 | Liquid |
| 纯化方式 | Antigen affinity purification |
| UNIPROT ID | Q9UJA2 |
| 储存缓冲液 | PBS with 0.02% sodium azide and 50% glycerol, pH 7.3. |
| 储存条件 | Store at -20°C. Stable for one year after shipment. Aliquoting is unnecessary for -20oC storage. |
背景介绍
Cardiolipin (CL) is a mitochondrial-specific double negatively charged phospholipid which is intricately involved in regulating bioenergetic efficiency. In eukaryotes, CL is synthesized by cardiolipin synthase (CRLS1 or CLS1) which catalyzes the reversible phosphatidyl group transfer from one phosphatidylglycerol molecule to another to form CL and glycerol. Recently it has been reported that transgenic expression of CRLS1 accelerates cardiolipin remodeling, improves mitochondrial function, modulates mitochondrial signaling, and attenuates mitochondrial dysfunction during diabetes, thereby identifying CRLS1 as a novel therapeutic target to attenuate mitochondrial dysfunction in diabetic myocardium. The predicted molecular weight of CRLS1 is around 32-35 kDa, while a 50 kDa protein with CRLS1 activity had been observed in liver isolation, which may represent an isoform of CRLS1 (20652826).
实验方案
| Product Specific Protocols | |
|---|---|
| IHC protocol for CRLS1-Specific antibody 14845-1-AP | Download protocol |
| WB protocol for CRLS1-Specific antibody 14845-1-AP | Download protocol |
| Standard Protocols | |
|---|---|
| Click here to view our Standard Protocols |
发表文章
| Species | Application | Title |
|---|---|---|
EMBO J Cristae formation is a mechanical buckling event controlled by the inner mitochondrial membrane lipidome
| ||
J Nutr Biochem Deficiency of β-carotene oxygenase 2 induces mitochondrial fragmentation and activates the STING-IRF3 pathway in the mouse hypothalamus. | ||
Front Mol Neurosci Cardiolipin externalization mediates prion protein (PrP) peptide 106-126-associated mitophagy and mitochondrial dysfunction | ||
J Biol Chem Myocardial regulation of lipidomic flux by cardiolipin synthase: setting the beat for bioenergetic efficiency. | ||
Neural Regen Res Neuroprotective effects of Alda-1 mitigate spinal cord injury in mice: involvement of Alda-1-induced ALDH2 activation-mediated suppression of reactive aldehyde mechanisms. | ||
Physiol Behav Exercise ameliorates high-fat diet-induced insulin resistance accompanied by changes in protein levels of hepatic ATF3-related signaling in rats. |